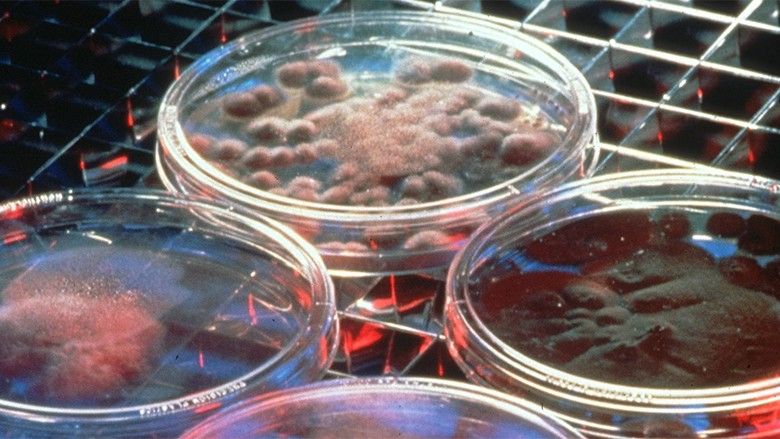
2016/05/NF-July8-A-Low-Methionine-Diet-May-Help-Starve-Cancer-Cells.jpg

Fillon fushata për vetëdijësimin e qytetarëve të Maqedonisë për rrezikun e kancerit
31/05/2017
Me rastin e dhjetëvjetorit të themelimit, shoqata ''Borka'' dhe agjencia kreative ''P World'' fillojnë fushatën për ngritjen e vetëdijes për kancerin, përcjell Telegrafi Maqedoni.
Qëllimi i fushatës është që t'u bëhet e ditur qytetarëve për seriozitetin e këtij problemi, si edhe të nxitin institucionet shtetërore dhe shëndetërore për të ndërmarrë aktivitete në drejtim të zgjidhjes së këtyre problemeve kërcënuese për jetën e qytetarëve.
Në Maqedoni, 20 pacientë të rinj diagnostifikohen me kancer, kurse 13 pacientë në ditë vdesin nga kanceri./Telegrafi/